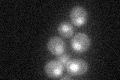
YNL250W
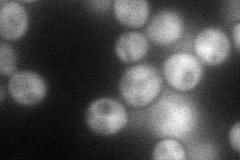
YNL250W
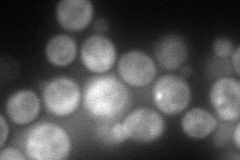
YNL250W
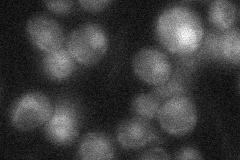
YNL250W
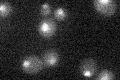
YNL250W

View description
Subunit of MRX complex, with Mre11p and Xrs2p, involved in processing double-strand DNA breaks in vegetative cells, initiation of meiotic DSBs, telomere maintenance, and nonhomologous end joining
Localization:
Intensity:
Fold change:
Significance:
-
C’ GFP library in SD
nucleus24.95 -
N' NOP1pr-GFP in SD
cytosol85.621 -
N' TEF2pr-mCherry in SD
punctate103.791 -
N' NATIVEpr-GFP in SD
nucleus24.2364 -
N' TEF2pr-VC and Cyto-VN in SD

cytosol28.9177 -
C’ GFP library in SD+DTT

nucleus22.730.91No -
C’ GFP library in SD+H2O2

nucleus26.661.06No -
C’ GFP library in Starvation Media
nucleus20.310.81No -
C’ GFP library on the background of Pup2-DaMP

nucleus -
C’ GFP library on the background of CCT mutant

nucleus24.1370.967331No
